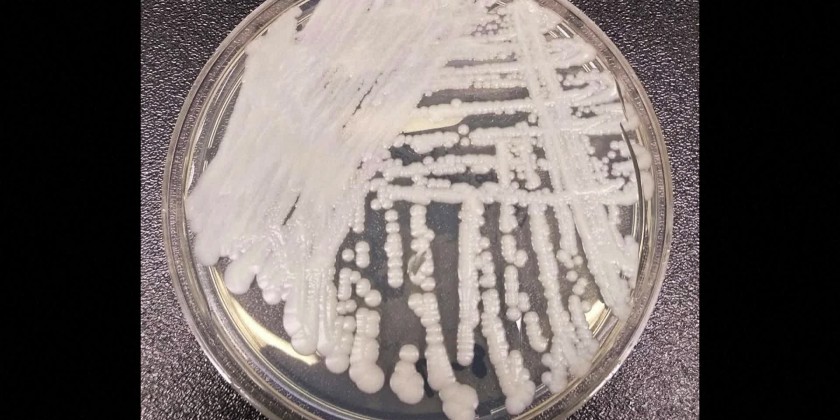

U.S. cases of a dangerous fungus tripled over just three years, and more than half of states have now reported it, according to a new study. The fungus, Candida auris, is a form of yeast that is usually not harmful to healthy people but can be a deadly risk to fragile hospital and nursing home patients.
It spreads easily and can infect wounds, ears and the bloodstream. Some strains are so-called superbugs that are resistant to all three classes of antibiotic drugs used to treat fungal infections. It was first identified in Japan in 2009. The first U.S. case occurred in 2013, but it was not reported until 2016.
The new study found cases have continued to shoot up, rising to 476 in 2019, to 756 in 2020, and then to 1,471 in 2021. Many of the first U.S. cases were infections that had been imported from abroad, but now most infections are spread within the US.
MITV is a broadcast TV brand intended for international and local English speaking consumers, launched on 31st March 2010 based in Yangon.